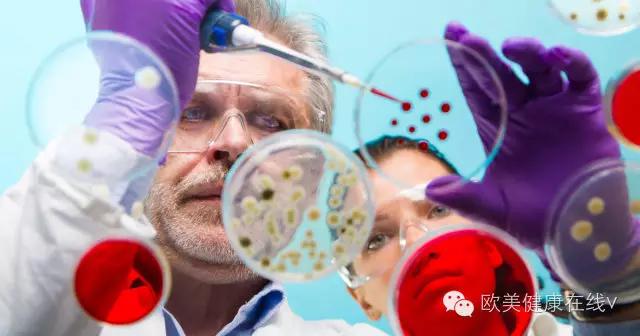
癌症的奇效良方,癌症新疗法

近日,全球最大的癌症会议——美国临床肿瘤学会(ASCO)年会在芝加哥召开,而精准医疗是今年年会的主题之一。医生们认为,癌症的治疗正在进入个性化医疗的“新时代”,将对每位患者的肿瘤弱点进行有针对性的用药。
研究人员对肿瘤认识的进步将用来解锁新的治疗方法。但目前也有担忧认为,尽管我们已经拥有一些精准医疗的药物,但是有些患者却与这些药物失之交臂。

什么是精准医疗? 精准医疗,是一种定制化医疗服务模式,通过在治疗决策、治疗过程、治疗产品等环节为个体提供个性化医疗服务。这种方法主要是通过在病人的基因信息或其他细胞层面分析的基础上产生的。
精准医疗的前提是,即使是在同一个组织中,癌症也并不都是一样的,因此需要为患者量身定制治疗方案。 这与足球比赛中使用的战术是一样的——当面对巴塞罗那、纽卡斯尔或者斯凯格内斯镇队时采取的战术是不同的。
DNA线索:寻找“癌症密码”癌症,是正常的细胞被DNA突变俘虏后,生长失去了控制而产生的。传统的化疗和放疗会杀死一切,包括在细胞里健康的组织。 而精准医疗的理念是对每一位患者的癌细胞进行检测,找到它的突变点,使用相应的靶向药物来治疗,对症下药。
现在这个概念并不稀奇,比如乳腺癌的患者都会进行肿瘤分析,以决定治疗方法。受到雌激素刺激生长的肿瘤,目前已经有阻断雌激素的药物来治疗,而药物赫赛汀(治疗乳腺癌的化疗药品)适用对象大概只占基因突变的患者20%。

但是遗传学的一场革命,让科学家能迅速地、花费较低地直击癌症中被损坏的DNA,引导新一代的精准药物。英国癌症中心的首席医生Peter Johnson认为:“找到癌症的靶点,并进行靶向治疗这种观点已经为大家所熟知,而接下来需要大家深入了解的是我们对此的认识。”
“我认为这是一个新的时代,它是由这些破译细胞遗传密码的技术更新所推进的,而技术带来的改变是15年前或20年前无法想象的。因此在此基础上,我们有治疗癌症的新机会。”

重大进展:化疗比例将大大降低这次全球最大的癌症会议有3万名医生和科学家出席,已经向大家展示精准医疗如何帮助我们战胜癌症。英国国家肺病矩阵正在试图为肺癌患者匹配新一代靶向药物,以适应患者肿瘤特有的缺陷。与此同时,另一项试验宣布将测试4500名乳腺癌患者,看看哪些患者需要接受化疗。
伦敦大学学院的顾问Robert Stein博士表示:“我们希望在试验能帮助降低三分之二的化疗比例,而相关精准用药的数据将在不久后公布。”

不该被错过的精准医疗精准医疗对患者是非常有益的,因为它的副作用要比化疗和放疗少得多。但是, 有些患者本来应该受益于已有的精准医疗,却因为种种原因错过了,如治疗肺癌的克唑替尼,或者黑色素瘤的达拉菲尼。英国癌症研究中心的一项分析报告发现,因为没有接受测试,这些患者并没有得到精准医疗。在英国每年就有10,900例肠癌患者,但是其中有4900名患者并没有得到精准药物的帮助。据估计,至少有2100名患者可以适用一种已经开发出来的精准药物,而在肺癌中有1400名患者错过了匹配的药物。

尽管如此,Johnson教授最后总结道:“我们此刻只是在精准医疗的准备阶段,在未来我们会将它充分应用到工作中,争取为每一位患者找到匹配他们的药物。”
如果大家想了解更多的医疗及健康相关信息,赶紧添加“countonchina”的微信咨询吧,我们将在第一时间为您答疑。

